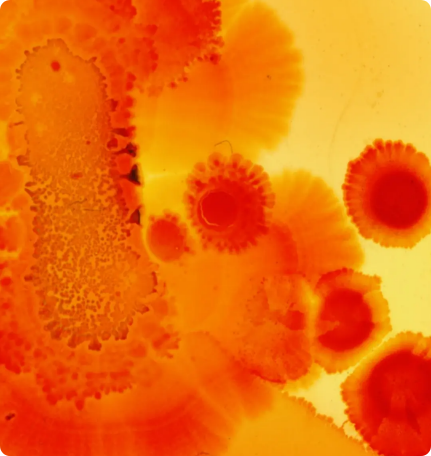

Core Cellular Enhancers

Nicotinamide Riboside (NR) 99.8%
EXPLORE

Nicotinamide Riboside (NR) 99.8%
Nicotinamide Riboside (NR) is a potent Vitamin B3 derivative that naturally boosts NAD+, essential for cellular health and energy.
Use:
Cellular Health & Repair
Anti-Aging
Energy Enhancement
Benefits:
Boosts NAD+ levels,Significantly increases cellular NAD+ levels
Promotes healthy aging, by improving cell resilience and function.
Enhances energy and well-being, elevates overall energy without the side effects commonly associated with caffeine, offering mental clarity and improved metabolism.
Widely present in the diet, efficient NAD+ BOOST beyond dietary sources
Promotes healthy aging, by improving cell resilience and function.
Enhances energy and well-being, elevates overall energy without the side effects commonly associated with caffeine, offering mental clarity and improved metabolism.
Widely present in the diet, efficient NAD+ BOOST beyond dietary sources
About:
Though NR is widespread in the diet—present in fruits, vegetables, meats, and especially dairy products—the amount required to significantly impact NAD+ levels is beyond everyday consumption. For example, one would need to drink over 1,300 cups of milk to match the NR content found in one 300mg capsule of Longevitan’s formula. While yeast also contains NR and potentially in higher concentrations due to its niacin content, the exact NR amounts in fermented products like beer remain unclear and vary by brand and brewing methods.
Relying on diet alone for NR intake, especially from milk, yeast, or fermented foods, is impractical and insufficient for meaningful health benefits. Thus, supplementing with Longevitan’s Epigeno Recharge+, which extracts and refines NR to a purity of 99.8%, becomes an essential strategy for anyone looking to enhance their NAD+ levels effectively. This approach bypasses the need for excessive consumption of specific foods, offering a straightforward and impactful way to support cellular vitality and longevity.
Relying on diet alone for NR intake, especially from milk, yeast, or fermented foods, is impractical and insufficient for meaningful health benefits. Thus, supplementing with Longevitan’s Epigeno Recharge+, which extracts and refines NR to a purity of 99.8%, becomes an essential strategy for anyone looking to enhance their NAD+ levels effectively. This approach bypasses the need for excessive consumption of specific foods, offering a straightforward and impactful way to support cellular vitality and longevity.

Lycopene 20.3%
EXPLORE

Lycopene 20.3%
Lycopene is a naturally occurring antioxidant found in tomatoes and other red fruits and vegetables, celebrated for its heart health and cancer-preventative properties.
Use:
Antioxidant Support
Heart Health
Skin Protection
Benefits:
Acts as a potent antioxidant, reducing the risk of chronic diseases.
Supports heart health by lowering blood pressure and reducing the risk of heart diseases.
Protects the skin from UV damage and promotes a healthy complexion.
May reduce the risk of certain types of cancers, particularly prostate cancer.
Supports bone health by reducing oxidative stress and inflammation.
Supports heart health by lowering blood pressure and reducing the risk of heart diseases.
Protects the skin from UV damage and promotes a healthy complexion.
May reduce the risk of certain types of cancers, particularly prostate cancer.
Supports bone health by reducing oxidative stress and inflammation.
About:
Lycopene, with its 20.3% concentration in Epigeno Recharge+, offers robust antioxidant protection, shielding the body from the harmful effects of free radicals and contributing to a reduced risk of chronic conditions. Its heart health benefits are particularly noteworthy, making it an essential nutrient for cardiovascular wellbeing. By including Lycopene, Epigeno Recharge+ taps into the power of natural compounds to offer a protective, health-enhancing boost to the body’s defense systems, underscoring the importance of diet and nutrition in maintaining health and preventing disease.
Through the careful selection and integration of these potent ingredients, Epigeno Recharge+ represents a comprehensive approach to health and wellness, targeting cellular repair, antioxidant protection, cardiovascular health, and beyond, embodying a holistic strategy for aging gracefully and healthily.
Through the careful selection and integration of these potent ingredients, Epigeno Recharge+ represents a comprehensive approach to health and wellness, targeting cellular repair, antioxidant protection, cardiovascular health, and beyond, embodying a holistic strategy for aging gracefully and healthily.

Pterostilbene: 99.8%
EXPLORE

Pterostilbene: 99.8%
Pterostilbene is a naturally occurring polyphenol, similar to resveratrol, found in blueberries and grapes, celebrated for its antioxidant properties and supportive role in cellular health.
Use:
Antioxidant Support
Cognitive Health
Longevity
Benefits:
Provides powerful antioxidant support, combating oxidative stress.
Enhances cognitive functions and brain health.
Supports longevity by promoting healthy cellular function.
Aids in maintaining healthy cholesterol levels for cardiovascular health.
Supports mood regulation and mental well-being.
Enhances cognitive functions and brain health.
Supports longevity by promoting healthy cellular function.
Aids in maintaining healthy cholesterol levels for cardiovascular health.
Supports mood regulation and mental well-being.
About:
Pterostilbene, a naturally occurring polyphenol found abundantly in blueberries and grapes, is celebrated for its antioxidant properties and supportive role in cellular health. Similar to resveratrol but with greater bioavailability and efficacy within the body, Pterostilbene provides powerful antioxidant support, combating oxidative stress, enhancing cognitive functions and brain health, and promoting longevity by supporting healthy cellular function.
It also aids in maintaining healthy cholesterol levels for cardiovascular health and supports mood regulation and mental well-being.
With its high purity of 99.8%, Pterostilbene is a beacon of cellular defense and cognitive support, playing a pivotal role in neutralizing free radicals and protecting cells from oxidative damage. Its inclusion in Epigeno Recharge+ underscores a commitment to harnessing nature's most potent compounds, like those found abundantly in blueberries, for optimizing health and wellness, offering a multifaceted approach to aging, brain health, and overall vitality.
Each component of Epigeno Recharge+ is meticulously selected for its proven benefits, contributing to a holistic approach to health that supports cellular vitality, metabolic balance, and cognitive clarity, ensuring that you're not just living longer but living better.
It also aids in maintaining healthy cholesterol levels for cardiovascular health and supports mood regulation and mental well-being.
With its high purity of 99.8%, Pterostilbene is a beacon of cellular defense and cognitive support, playing a pivotal role in neutralizing free radicals and protecting cells from oxidative damage. Its inclusion in Epigeno Recharge+ underscores a commitment to harnessing nature's most potent compounds, like those found abundantly in blueberries, for optimizing health and wellness, offering a multifaceted approach to aging, brain health, and overall vitality.
Each component of Epigeno Recharge+ is meticulously selected for its proven benefits, contributing to a holistic approach to health that supports cellular vitality, metabolic balance, and cognitive clarity, ensuring that you're not just living longer but living better.

Proanthocyanidins: 98%
EXPLORE

Proanthocyanidins: 98%
Proanthocyanidins are a class of powerful antioxidants found in grape seeds, apples, and berries, known for their ability to support cardiovascular health and skin vitality.
Use:
Antioxidant Protection
Skin Health
Cardiovascular Support
Benefits:
Offers potent antioxidant protection to combat free radical damage.
Supports skin health by improving elasticity and hydration.
Aids in maintaining cardiovascular health and reducing blood pressure.
Supports urinary tract health and reduces the risk of infections.
Enhances vision health by protecting the eyes from oxidative stress.
Supports skin health by improving elasticity and hydration.
Aids in maintaining cardiovascular health and reducing blood pressure.
Supports urinary tract health and reduces the risk of infections.
Enhances vision health by protecting the eyes from oxidative stress.
About:
Proanthocyanidins, with their impressive 98% purity, stand out for their strong antioxidant properties, providing a shield against cellular damage induced by oxidative stress. These compounds are not only celebrated for their health-promoting benefits but also for their role in supporting the integrity of collagen and elastin in the skin, promoting a youthful appearance. By incorporating Proanthocyanidins into Epigeno Recharge+, the formula leverages the power of nature to enhance cardiovascular function, skin health, and overall wellbeing, making it an essential component of a health-conscious lifestyle.
Natural Plant Extracts for Holistic Health

Grape Seed Extract
EXPLORE

Grape Seed Extract
Grape Seed Extract is derived from the potent seeds of grapes, a powerhouse of antioxidants known as oligomeric proanthocyanidin complexes (OPCs). This extract is celebrated for its cardiovascular benefits, skin health enhancement, and its role in protecting the body against oxidative stress.
Use:
Antioxidant Protection
Cardiovascular Health
Skin Elasticity and Radiance
Benefits:
Provides strong antioxidant support, reducing oxidative stress and inflammation.
Improves circulatory health by strengthening blood vessels and improving blood flow.
Promotes skin elasticity and health, contributing to a youthful appearance.
Supports eye health by reducing the risk of degeneration and improving night vision.
Aids in bone strength and health, promoting overall skeletal wellbeing.
Improves circulatory health by strengthening blood vessels and improving blood flow.
Promotes skin elasticity and health, contributing to a youthful appearance.
Supports eye health by reducing the risk of degeneration and improving night vision.
Aids in bone strength and health, promoting overall skeletal wellbeing.
About:
Sourced from the finest grapes, our Grape Seed Extract is concentrated through an advanced extraction process to ensure maximum potency and purity. The process captures the essence of OPCs, delivering unparalleled antioxidant support. Unlike the minimal amounts found in dietary consumption of grapes, our extract provides a powerful, concentrated dose of these beneficial compounds. Its inclusion in Longevitan's Epigeno Recharge+ offers a direct and efficient way to harness the cardiovascular and skin health benefits of Grape Seed Extract, enhancing the supplement's overall efficacy.

Tomato Extract
EXPLORE
Tomato Extract
Tomato Extract is a nutrient-dense concentrate sourced from tomatoes, rich in lycopene, vitamins, and minerals. It is renowned for its antioxidant properties, support for heart health, and protective benefits for the skin against UV damage.
Use:
Heart Health
Skin Protection and Vitality
Immune Support
Benefits:
Rich in lycopene, providing antioxidant protection and supporting heart health.
Promotes skin vitality by protecting against UV damage and improving skin texture.
Enhances immune function with a broad spectrum of vitamins and minerals.
Supports healthy vision and may reduce the risk of age-related eye conditions.
Aids in the prevention of inflammation and lowers cholesterol levels.
Promotes skin vitality by protecting against UV damage and improving skin texture.
Enhances immune function with a broad spectrum of vitamins and minerals.
Supports healthy vision and may reduce the risk of age-related eye conditions.
Aids in the prevention of inflammation and lowers cholesterol levels.
About:
Our Tomato Extract emphasizes the healthful benefits of lycopene, a compound giving tomatoes their characteristic red color. Utilizing a refined extraction technique, we ensure that the integrity of lycopene and other vital nutrients is preserved, delivering them in a form that's more concentrated than what you'd typically obtain from diet alone. In Longevitan's Epigeno Recharge+, Tomato Extract synergizes with other ingredients to provide a multifaceted approach to wellness, focusing on heart health, skin vitality, and immune support. This makes the supplement a comprehensive tool for those seeking to improve their health naturally and effectively.
Essential Minerals for Balanced Wellness

Magnesium
EXPLORE

Magnesium
Magnesium is an essential mineral involved in over 300 biochemical reactions in the body, crucial for energy production, muscle and nerve function, and maintaining a healthy heart and bones.
Use:
Energy Production
Muscle And Nerve Function
Bone Health
Benefits:
Supports energy production, playing a key role in converting food into energy.
Crucial for muscle and nerve function, aiding in relaxation and reducing cramps.
Contributes to bone health by aiding in the formation of bone density.
Supports heart health by regulating heart rhythm and blood pressure.
Aids in managing stress and improving mood through its calming effects on the nervous system.
Crucial for muscle and nerve function, aiding in relaxation and reducing cramps.
Contributes to bone health by aiding in the formation of bone density.
Supports heart health by regulating heart rhythm and blood pressure.
Aids in managing stress and improving mood through its calming effects on the nervous system.
About:
Magnesium's pivotal role in energy production and physiological functions makes it an indispensable part of the Epigeno Recharge+ formula. Its wide-ranging benefits for physical and mental health reflect the mineral’s importance in diet and supplementation. The inclusion of magnesium addresses common deficiencies and supports the body’s natural processes, from muscle function to stress management, highlighting the formula's holistic approach to health and wellness.

Chloride
EXPLORE

Chloride
Chloride is an essential electrolyte that helps maintain proper fluid balance in the body and plays a crucial role in producing stomach acid for digestion.
Use:
Fluid Balance
Digestion
Nerve Function
Benefits:
Maintains the body's natural balance of fluids, essential for hydration and health.
Supports digestion by aiding in the production of hydrochloric acid in the stomach.
Crucial for transmitting nerve impulses, supporting muscle movement and nervous system function.
Helps regulate blood pressure and volume, contributing to cardiovascular health.
Assists in the transport of nutrients and waste products between cells.
Supports digestion by aiding in the production of hydrochloric acid in the stomach.
Crucial for transmitting nerve impulses, supporting muscle movement and nervous system function.
Helps regulate blood pressure and volume, contributing to cardiovascular health.
Assists in the transport of nutrients and waste products between cells.
About:
Chloride's inclusion in Epigeno Recharge+ highlights its fundamental role in maintaining fluid balance and supporting digestion. As one of the body's main electrolytes, chloride is vital for overall physiological function, from nerve transmission to digestive health. This ingredient ensures that the formula addresses essential aspects of health, reinforcing the body’s ability to maintain balance and function optimally.

Sodium
EXPLORE

Sodium
Sodium is a crucial electrolyte that helps maintain fluid balance, supports nerve function, and is essential for muscle contractions.
Use:
Fluid Balance
Nerve And Muscle Function
Benefits:
Maintains fluid balance, critical for cellular function and overall hydration.
Essential for nerve transmission, supporting communication within the nervous system.
Supports muscle function, including necessary muscle contractions.
Regulates blood pressure and volume, contributing to cardiovascular health.
Plays a role in nutrient absorption and transport across cell membranes.
Essential for nerve transmission, supporting communication within the nervous system.
Supports muscle function, including necessary muscle contractions.
Regulates blood pressure and volume, contributing to cardiovascular health.
Plays a role in nutrient absorption and transport across cell membranes.
About:
Sodium’s role in Epigeno Recharge+ is crucial for ensuring that the body's fluid levels remain balanced and that nerve and muscle functions are supported. While often misunderstood due to its association with high blood pressure, sodium in appropriate amounts is vital for health and well-being. Its careful inclusion in the formula addresses the body's needs for this essential mineral, promoting optimal physiological functions and supporting overall health.
Each of these ingredients contributes to the multifaceted benefits of Epigeno Recharge+, designed to support cellular health, energy levels, and overall vitality. By harnessing the power of these natural compounds, Epigeno Recharge+ offers a comprehensive approach to wellness, targeting the foundations of health at a cellular level.
Each of these ingredients contributes to the multifaceted benefits of Epigeno Recharge+, designed to support cellular health, energy levels, and overall vitality. By harnessing the power of these natural compounds, Epigeno Recharge+ offers a comprehensive approach to wellness, targeting the foundations of health at a cellular level.
Epigeno Recharge+ Attributes
Free Of


Artificial Sweeteners
Avoids synthetic sweeteners, opting for natural sources.


Gluten
Safe for individuals with gluten intolerance or celiac disease.


Dairy or Lactose
Suitable for those avoiding dairy due to intolerance or dietary choices.


Eggs or Peanuts
Free from common allergens, making it accessible to more people.


Soy
Ideal for those avoiding soy due to allergies or dietary preferences.


Tired of settling for ordinary supplements?
Epigeno™ Recharge+ goes beyond basic nutrition, offering a powerful blend of science-backed ingredients designed to optimize your cellular health and promote a longer, healthier life.
Customer Reviews: Real Experiences, Real Feelings
Join the thousands who are already experiencing the transformative power of Epigeno Recharge+
Have a question?We are happy to help.
Check out the most common questions our customers asked. Still have questions?
Contact our customer support.
Contact our customer support.
Our customer support is available Monday to Friday: 9am - 5pm.
Average answer time: 12h
● FAQS
01Is Epigeno Recharge+ suitable for vegetarians or vegans?
-+
Yes, Epigeno Recharge+ is formulated to be both vegetarian and vegan-friendly, containing no animal-derived ingredients or by-products. This makes it suitable for individuals following plant-based diets.
02How should Epigeno Recharge+ be stored?
-+
To maintain its potency and effectiveness, Epigeno Recharge+ should be stored in a cool, dry place away from direct sunlight. Keep the bottle tightly closed when not in use to protect it from moisture and air.
03Can Epigeno Recharge+ help with weight management?
-+
While Epigeno Recharge+ is not specifically marketed as a weight management supplement, its components support cellular metabolism and energy levels, which could complement a healthy diet and exercise regime aimed at weight management. As with any supplement, individual results may vary.
04Are there any contraindications for Epigeno Recharge+?
-+
As with any dietary supplement, individuals with pre-existing medical conditions, those taking prescription medications, or with specific health concerns, should consult a healthcare provider before starting Epigeno Recharge+.
05Can Epigeno Recharge+ improve athletic performance?
-+
Epigeno Recharge+ is designed to support overall cellular health and energy levels, which may indirectly benefit athletic performance and recovery. However, it's important to combine supplementation with proper training and nutrition for the best results.
06Does Epigeno Recharge+ contain any allergens?
-+
Epigeno Recharge+ is formulated without common allergens such as gluten, dairy, eggs, peanuts, and soy, making it suitable for individuals with allergies to these components.
07Is there a best time of day to take Epigeno Recharge+?
-+
It is recommended to take Epigeno Recharge+ with breakfast or lunch. Taking it early in the day can help ensure that its energizing effects align with your daily activities and natural circadian rhythms.
08What makes Epigeno Recharge+ different from other NAD+ supplements?
-+
Epigeno Recharge+ distinguishes itself with its high-quality, rigorously tested ingredients, including a high-purity NR, and the inclusion of additional antioxidants and compounds designed to synergistically enhance the formula's effectiveness and support overall well-being.
09Can I take Epigeno Recharge+ on an empty stomach?
-+
While it is generally recommended to take Epigeno Recharge+ with food to enhance absorption, it can be taken on an empty stomach if preferred. However, individuals with sensitive stomachs may benefit from eating it with a meal.
010What is Nicotinamide Riboside and how does it benefit me?
-+
Nicotinamide Riboside (NR) is a form of Vitamin B3 that naturally boosts NAD+ levels in the body, crucial for energy production, DNA repair, and overall cellular health. Supplementing with NR can enhance cellular repair, support anti-aging efforts, and improve energy and well-being.
011Can I get enough NR from my diet alone?
-+
While NR is found in foods like dairy, eggs, meat, and vegetables, the concentration is too low to significantly impact NAD+ levels. For example, you'd need to consume over 1,300 cups of milk to match the NR content in one capsule of Longevitan’s formula. Supplementing with Longevitan’s Epigeno Recharge+ provides an efficient, direct way to boost your NAD+ levels.
012Why are minerals like Chloride, Magnesium, and Sodium included in Epigeno Recharge+?
-+
These essential minerals support a balanced wellness. Chloride maintains fluid balance and aids digestion. Magnesium is crucial for energy production, muscle and nerve function, and bone health. Sodium helps maintain fluid balance and supports nerve and muscle functions. Together, they ensure the body’s physiological functions are optimized.
013Is it safe to take Epigeno Recharge+ every day?
-+
Yes, Epigeno Recharge+ is designed for daily use. Its ingredients, including Nicotinamide Riboside, are naturally occurring compounds that are safe for long-term consumption when used as directed.

Committed to Pure Performance for Longevity
At Epigeno, we're committed to empowering your longevity journey with clean, science-backed formulas. We believe you start with pure ingredients, which is why we have a stringent "Transparency Pledge" that guides our product development.

Unveiling the Power of Clean Ingredients
We believe in harnessing the power of nature to promote optimal cellular health and longevity. Each Longevitan product is meticulously formulated with a blend of scientifically studied, clean ingredients designed to support specific health goals.specific health goals.